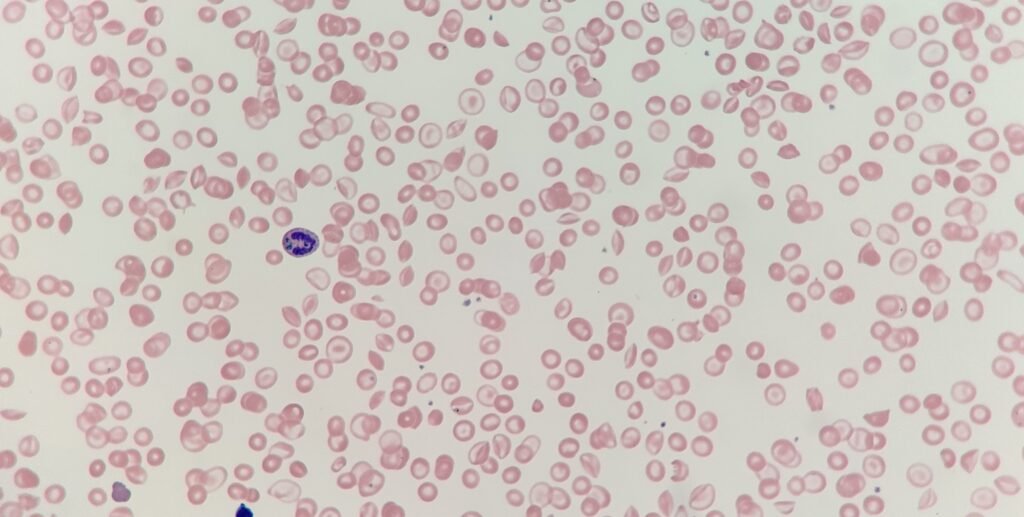
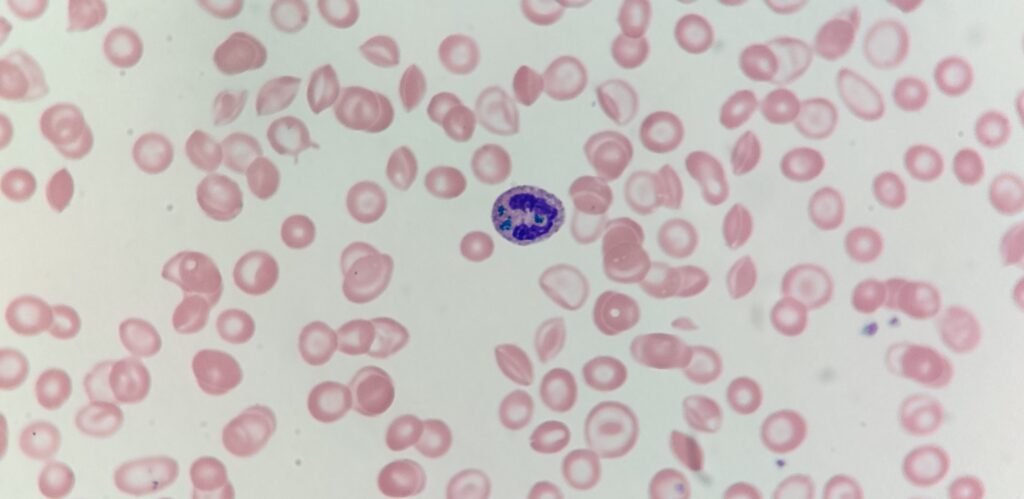

This week’s case features a patient currently in the Intensive Care Unit (ICU) suffering from acute liver failure. The laboratory data and the resulting blood film provide a sobering look at the systemic impact of hepatic collapse.
The clinical context:
The patient’s FBC reveals a somewhat complex picture:
- Hb: 67 g/L
- PLT: 41 x 109/L
- WBC: 8.1 x 109/L
While reviewing the blood film, the biomedical scientist noticed abnormalities in the red cells, but also interestingly some inclusions with the neutrophils.

The challenge:
- What are the inclusions within the neutrophils called? They are sometimes referred to by a particularly ominous nickname.
- In the context of liver failure, what does the presence of these inclusions signify for the patient’s prognosis?
- Aside from the neutrophil findings, what red cell features can you see on the film?
Feel free to follow along on LinkedIn or on Twitter (X).
2 Comments
Blue green crystals of death. Probable liver failure. Poor prognosis. Patient has an associated haemoglobinopathy.
The inclusion is the blue crystal of death, it means an acute liver failure (patient is critically ill). Patient might have an ongoing haemoglobinopathy. ?HbC/beta thalassaemia, as there is a presence of HbC crystals, and boat shaped red cells.